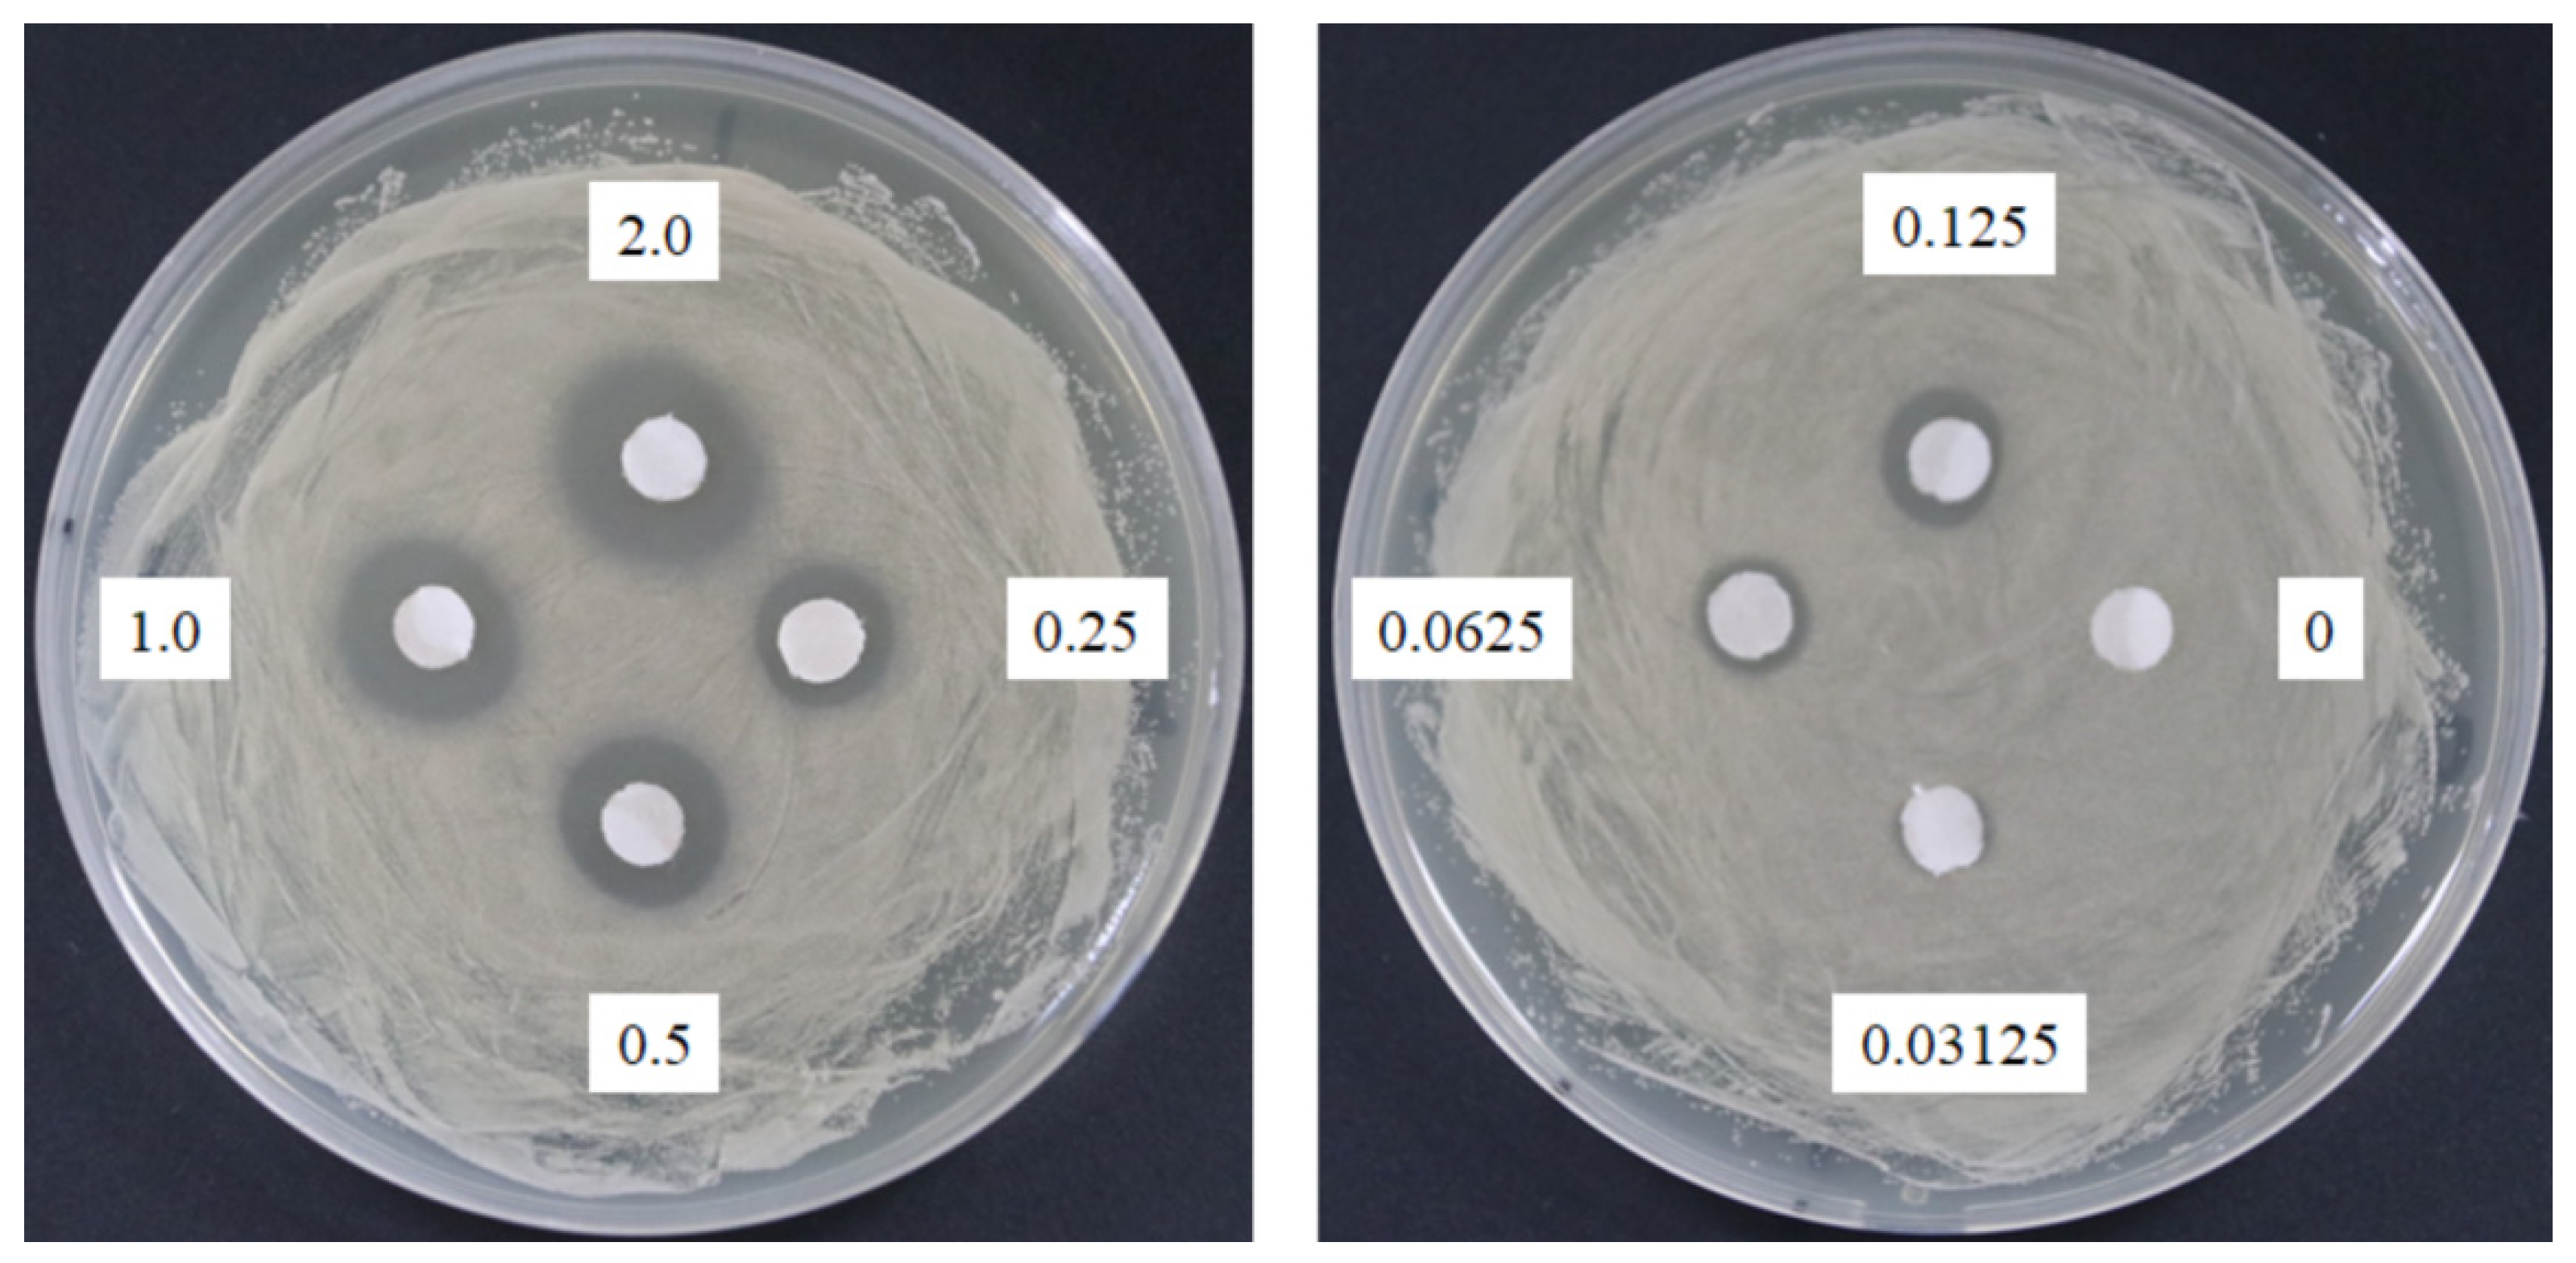
Molecules 24 01587 g008

Anticandidal Potential of Stem Bark Extract from Schima superba and the Identification of Its Major Anticandidal Compound
Abstract
1. Introduction
2. Results
2.1. Antioxidant Activity of SSE
2.2. Antimicrobial Assay of SSE
2.3. Total Polyphenol and Saponin Determination of SSE
2.4. RNA-seq Analysis of C. Albicans with SSE Treatment
2.5. SEM of C. Albicans with SSE Treatment
2.6. Saponin Identification from SSE by UPLC, ESI-MS and NMR Analyses
3. Discussion
4. Materials and Methods
4.1. Plant Material and Extraction
4.2. Antioxidant Activity by 2,2-diphenyl-1-picrylhydrazyl (DPPH) Radical Scavenging Assay
4.3. Antioxidant Activity by ABTS+ Radical Scavenging Assay
4.4. Antimicrobial Assay
4.5. Detection of Total Polyphenols and Saponins
4.6. RNA-Seq Analysis of C. Albicans
4.7. Quantitation of Gene Expression by Real-Time RT-PCR
4.8. SEM Analysis
4.9. Purification and Identification of SSE by UPLC, ESI-MS, and NMR Analyses
5. Conclusions
Supplementary Materials
Author Contributions
Funding
Conflicts of Interest
References
- College, J.N.M. Traditional Chinese Medicine (1st Volume); Shanghai Scientific & Technical Publishers: Shanghai, China, 1985. [Google Scholar]
- Xu, W.; Zhou, G.X.; Dai, Y.; Yao, X.S. Chemical constituents in stems of Schima superba. Chin. Trad. Herb. Drugs 2010, 41, 863–866. [Google Scholar]
- Zhang, T.J.; Zheng, J.; Yu, Z.C.; Huang, X.D.; Zhang, Q.L.; Tian, X.S.; Peng, C.L. Functional characteristics of phenolic compounds accumulated in young leaves of two subtropical forest tree species of different successional stages. Tree Physiol. 2018, 38, 1486–1501. [Google Scholar] [CrossRef] [PubMed]
- Daglia, M. Polyphenols as antimicrobial agents. Curr. Opin. Biotechnol. 2012, 23, 174–181. [Google Scholar] [CrossRef]
- Huo, G.H.; Chen, X.T.; Li, Z.M.; Liu, C.F.; Xiao, D.J. Synthesis and structure-activity relationship of theasapogenol galactosides against Magnaporthe oryzae. J. Asian Nat. Prod. Res. 2018, 20, 128–138. [Google Scholar] [CrossRef] [PubMed]
- Huo, G.; Zhang, C.; Zhang, Y. Structure elucidation of two triterpenoid saponins from leaves of Schima superba Gardn. et Champ. Lec. Notes Elec. Eng. 2014, 250, 915–922. [Google Scholar]
- Xu, W.; Wang, H.; Zhou, G.X.; Yao, X.S. Two new 8-O-4′-type lignans from the stem of Schima superba and their cell growth inhibitory activities against human cancer cell lines. J. Asian Nat. Prod. Res. 2010, 12, 874–878. [Google Scholar] [CrossRef]
- Wu, C.; Zhang, R.L.; Li, H.Y.; Hu, C.; Liu, B.L.; Li, Y.L.; Zhou, G.X. Triterpenoid saponins from the root bark of Schima superba and their cytotoxic activity on B16 melanoma cell line. Carbohydr. Res. 2015, 413, 107–114. [Google Scholar] [CrossRef]
- Polesello, V.; Segat, L.; Crovella, S.; Zupin, L. Candida infections and human defensins. Protein Pept. Lett. 2017, 24, 747–756. [Google Scholar] [CrossRef]
- De Backer, M.D.; Ilyina, T.; Ma, X.J.; Vandoninck, S.; Luyten, W.H.; Vanden Bossche, H. Genomic profiling of the response of Candida albicans to itraconazole treatment using a DNA microarray. Antimicrob. Agents Chemother. 2001, 45, 1660–1670. [Google Scholar] [CrossRef] [PubMed]
- Zavrel, M.; White, T.C. Medically important fungi respond to azole drugs: An update. Future Microbiol. 2015, 10, 1355–1373. [Google Scholar] [CrossRef]
- Wiederhold, N.P. Antifungal resistance: Current trends and future strategies to combat. Infect. Drug Resist. 2017, 10, 249–259. [Google Scholar] [CrossRef] [PubMed]
- Zida, A.; Bamba, S.; Yacouba, A.; Ouedraogo-Traore, R.; Guiguemde, R.T. Anti-Candida albicans natural products, sources of new antifungal drugs: A review. J. Mycol. Med. 2017, 27, 1–19. [Google Scholar] [CrossRef]
- Soberon, J.R.; Sgariglia, M.A.; Pastoriza, A.C.; Soruco, E.M.; Jager, S.N.; Labadie, G.R.; Sampietro, D.A.; Vattuone, M.A. Antifungal activity and cytotoxicity of extracts and triterpenoid saponins obtained from the aerial parts of Anagallis arvensis L. J. Ethnopharmacol. 2017, 203, 233–240. [Google Scholar] [CrossRef] [PubMed]
- Pereira, J.V.; Freires, I.A.; Castilho, A.R.; da Cunha, M.G.; Alves Hda, S.; Rosalen, P.L. Antifungal potential of Sideroxylon obtusifolium and Syzygium cumini and their mode of action against Candida albicans. Pharm. Biol. 2016, 54, 2312–2319. [Google Scholar] [CrossRef] [PubMed]
- Mapfunde, S.; Sithole, S.; Mukanganyama, S. In vitro toxicity determination of antifungal constituents from Combretum zeyheri. BMC Complement. Altern. Med. 2016, 16, 1–11. [Google Scholar] [CrossRef] [PubMed]
- Wang, M.Y.; Peng, Y.; Peng, C.S.; Qu, J.Y.; Li, X.B. The bioassay-guided isolation of antifungal saponins from Hosta plantaginea leaves. J. Asian Nat. Prod. Res. 2018, 20, 501–509. [Google Scholar] [CrossRef]
- Hayes, B.M.; Bleackley, M.R.; Wiltshire, J.L.; Anderson, M.A.; Traven, A.; van der Weerden, N.L. Identification and mechanism of action of the plant defensin NaD1 as a new member of the antifungal drug arsenal against Candida albicans. Antimicrob. Agents Chemother. 2013, 57, 3667–3675. [Google Scholar] [CrossRef] [PubMed]
- Sanglard, D.; Kuchler, K.; Ischer, F.; Pagani, J.L.; Monod, M.; Bille, J. Mechanisms of resistance to azole antifungal agents in Candida albicans isolates from AIDS patients involve specific multidrug transporters. Antimicrob. Agents Chemother. 1995, 39, 2378–2386. [Google Scholar] [CrossRef] [PubMed]
- Chauhan, N.; Inglis, D.; Roman, E.; Pla, J.; Li, D.; Calera, J.A.; Calderone, R. Candida albicans response regulator gene SSK1 regulates a subset of genes whose functions are associated with cell wall biosynthesis and adaptation to oxidative stress. Eukaryot. Cell 2003, 2, 1018–1024. [Google Scholar] [CrossRef] [PubMed]
- Matsuda, H.; Nakamura, S.; Fujimoto, K.; Moriuchi, R.; Kimura, Y.; Ikoma, N.; Hata, Y.; Muraoka, O.; Yoshikawa, M. Medicinal flowers. XXXI. Acylated oleanane-type triterpene saponins, Sasanquasaponins I-V, with antiallergic activity from the flower buds of Camellia sasanqua. Chem. Pharm. Bull. (Tokyo) 2010, 58, 1617–1621. [Google Scholar] [CrossRef]
- Klis, F.M.; de Groot, P.; Hellingwerf, K. Molecular organization of the cell wall of Candida albicans. Med. Mycol. 2001, 39, 1–8. [Google Scholar] [CrossRef] [PubMed]
- Nather, K.; Munro, C.A. Generating cell surface diversity in Candida albicans and other fungal pathogens. FEMS Microbiol. Lett. 2008, 285, 137–145. [Google Scholar] [CrossRef] [PubMed]
- Kaneko, Y.; Ohno, H.; Kohno, S.; Miyazaki, Y. Micafungin alters the expression of genes related to cell wall integrity in Candida albicans biofilms. Jpn. J. Infect. Dis. 2010, 63, 355–357. [Google Scholar]
- Zhao, S.; Wei, P.; Wu, M.; Zhang, X.; Zhao, L.; Jiang, X.; Hao, C.; Su, X.; Zhao, D.; Cheng, M. Design, synthesis and evaluation of benzoheterocycle analogues as potent antifungal agents targeting CYP51. Bioorg. Med. Chem. 2018. [Google Scholar] [CrossRef]
- Yang, Q.; Gao, L.; Tao, M.; Chen, Z.; Yang, X.; Cao, Y. Transcriptomics analysis of Candida albicans treated with Huanglian Jiedu decoction using RNA-seq. Evid. Based Complement. Alternat. Med. 2016, 2016, 3198249. [Google Scholar] [CrossRef]
- Lim, S.M.; Ahn, K.B.; Kim, C.; Kum, J.W.; Perinpanayagam, H.; Gu, Y.; Yoo, Y.J.; Chang, S.W.; Han, S.H.; Shon, W.J.; et al. Antifungal effects of synthetic human beta-defensin 3-C15 peptide. Restor. Dent. Endod. 2016, 41, 91–97. [Google Scholar] [CrossRef]
- Raja, V.; Ahmad, S.I.; Irshad, M.; Wani, W.A.; Siddiqi, W.A.; Shreaz, S. Anticandidal activity of ethanolic root extract of Juglans regia (L.): Effect on growth, cell morphology, and key virulence factors. J. Mycol. Med. 2017, 27, 476–486. [Google Scholar] [CrossRef]
- Singh, D.; Chaudhuri, P.K. Structural characteristics, bioavailability and cardioprotective potential of saponins. Integr. Med. Res. 2018, 7, 33–43. [Google Scholar] [CrossRef]
- De Lucca, A.J.; Boue, S.; Sien, T.; Cleveland, T.E.; Walsh, T.J. Silver enhances the in vitro antifungal activity of the saponin, CAY-1. Mycoses 2011, 54, e1–e9. [Google Scholar] [CrossRef]
- Renault, S.; De Lucca, A.J.; Boue, S.; Bland, J.M.; Vigo, C.B.; Selitrennikoff, C.P. CAY-1, a novel antifungal compound from cayenne pepper. Med. Mycol. 2003, 41, 75–81. [Google Scholar] [CrossRef] [PubMed]
- Segal, R.; Schlosser, E. Role of glycosidases in the membranlytic, antifungal action of saponins. Arch. Microbiol. 1975, 104, 147–150. [Google Scholar] [CrossRef] [PubMed]
- Bersuder, P.; Hole, M.; Smith, G. Antioxidants from a heated histidine-glucose model system. I: Investigation of the antioxidant role of histidine and isolation of antioxidants by high-performance liquid chromatography. J. Am. Oil Chem. Soc. 1998, 75, 181–187. [Google Scholar] [CrossRef]
- Torres, K.A.; Lima, S.M.; Ueda, S.M. Activity of the aqueous extract of Schinus terebinthifolius Raddi on strains of the Candida genus. Rev. Bras. Ginecol. Obstet. 2016, 38, 593–599. [Google Scholar] [PubMed]
- Mbosso Teinkela, J.E.; Assob Nguedia, J.C.; Meyer, F.; Vouffo Donfack, E.; Lenta Ndjakou, B.; Ngouela, S.; Tsamo, E.; Adiogo, D.; Guy Blaise Azebaze, A.; Wintjens, R. In vitro antimicrobial and anti-proliferative activities of plant extracts from Spathodea campanulata, Ficus bubu, and Carica papaya. Pharm. Biol. 2016, 54, 1086–1095. [Google Scholar] [CrossRef]
- Makkar, H.P.S.; Siddhuraju, P.; Becker, K. Plant Secondary Metabolities, 1st ed.; Human Press: Trenton, NJ, USA, 2007. [Google Scholar]
- Ju, Y.; Tian, H.; Zhang, R.; Zuo, L.; Jin, G.; Xu, Q.; Ding, X.; Li, X.; Chu, Z. Overexpression of OsHSP18.0-CI enhances resistance to bacterial leaf streak in rice. Rice (NY) 2017, 10, 12. [Google Scholar] [CrossRef]
- Kim, D.; Langmead, B.; Salzberg, S.L. HISAT: A fast spliced aligner with low memory requirements. Nat. Methods 2015, 12, 357–360. [Google Scholar] [CrossRef]
- Li, B.; Dewey, C.N. RSEM: Accurate transcript quantification from RNA-Seq data with or without a reference genome. BMC Bioinform. 2011, 12, 323. [Google Scholar] [CrossRef]
- Eisen, M.B.; Spellman, P.T.; Brown, P.O.; Botstein, D. Cluster analysis and display of genome-wide expression patterns. Proc. Natl. Acad. Sci. USA 1998, 95, 14863–14868. [Google Scholar] [CrossRef]
- de Hoon, M.J.; Imoto, S.; Nolan, J.; Miyano, S. Open source clustering software. Bioinformatics 2004, 20, 1453–1454. [Google Scholar] [CrossRef] [PubMed]
- Wang, L.; Feng, Z.; Wang, X.; Zhang, X. DEGseq: An R package for identifying differentially expressed genes from RNA-seq data. Bioinformatics 2010, 26, 136–138. [Google Scholar] [CrossRef]
- Ashburner, M.; Ball, C.A.; Blake, J.A.; Botstein, D.; Butler, H.; Cherry, J.M.; Davis, A.P.; Dolinski, K.; Dwight, S.S.; Eppig, J.T.; et al. Gene ontology: Tool for the unification of biology. The Gene Ontology Consortium. Nat. Genet. 2000, 25, 25–29. [Google Scholar] [CrossRef] [PubMed]
- Kanehisa, M.; Goto, S.; Hattori, M.; Aoki-Kinoshita, K.F.; Itoh, M.; Kawashima, S.; Katayama, T.; Araki, M.; Hirakawa, M. From genomics to chemical genomics: New developments in KEGG. Nucleic Acids Res. 2006, 34, D354–D357. [Google Scholar] [CrossRef] [PubMed]
Sample Availability: Samples of the S. superba (SSE) are available from the authors. |

| Function | ID in GenBank | Protein | Annotation | Size (aa) | log2 Ratio | |
|---|---|---|---|---|---|---|
| 0.2 mg/mL | 0.4 mg/mL | |||||
| Ergosterol biosynthesis | XP_711894.1 | ERG1 | squalene monooxygenase | 496 | −0.30 | −0.12 |
| XP_713577.1 | ERG3 | C-5 sterol desaturase | 386 | −1.72 | −1.84 | |
| XP_722612.2 | ERG7 | Lanosterol synthase | 728 | −0.42 | −0.73 | |
| XP_722678.1 | ERG8 | Phosphomevalonate kinase | 432 | 0.93 | 1.18 | |
| XP_714460.2 | ERG9 | Bifunctional farnesyl-diphosphate farnesyltransferase/squalene synthase | 448 | 0.26 | 0.34 | |
| XP_716761.1 | ERG11 | Lanosterol 14α-demethylase | 528 | 0.43 | 0.89 | |
| XP_722703.1 | ERG251 | Methylsterol monooxygenase | 321 | −0.98 | −1.14 | |
| XP_715564.1 | ERG26 | Sterol-4-alpha-carboxylate 3-dehydrogenase | 350 | 0.20 | 0.14 | |
| XP_717931.1 | ERG27 | 3-Ketosteroid reductase | 346 | 1.22 | 1.17 | |
| Multidrug resistance | XP_712090.2 | ATM1 | ATP-binding cassette Fe/S cluster precursor transporter | 750 | −0.46 | −0.64 |
| XP_718280.1 | MDL1 | ATP-binding cassette permease | 685 | −0.16 | −0.85 | |
| XP_717637.1 | MLT1 | ATP-binding cassette | 1606 | 0.44 | 0.96 | |
| XP_719165.2 | MDR1 | Multidrug resistance protein: plasma membrane MDR/MFS multidrug efflux pump | 564 | 1.25 | 2.27 | |
| XP_721489.2 | HOL1 | Multidrug resistance protein: MFS transporter | 586 | 0.92 | 1.72 | |
| XP_712971.2 | HOL4 | Multidrug resistance protein: ion transporter | 624 | −0.5 | −0.73 | |
| XP_714342.2 | QDR3 | Multidrug resistance protein: membrane transporter | 697 | −0.59 | −0.95 | |
| KGU11486.1 | CDR1 | Multidrug resistance protein | 1501 | −1.65 | −2.4 | |
| Chitin degradation | XP_718674.1 | CHT1 | Putative Zn(II)2Cys6 transcription factor | 1389 | 1.14 | 1.33 |
| XP_721807.2 | CHT2 | GPI-linked chitinase | 1752 | −0.51 | −1.33 | |
| XP_722560.1 | CHT4 | Chitinase | 1167 | 2.37 | 2.62 | |
| No. | 1 | Sasanquasaponin III a | No. | 1 | Sasanquasaponin III a |
|---|---|---|---|---|---|
| 1 | 38.8 | 38.8 | 22-O-Ang 1‴″ | 167.8 | 167.7 |
| 2 | 26.3 | 26.3 | 2‴″ | 129.2 | 129.7 |
| 3 | 89.9 | 89.6 | 3‴″ | 136.5 | 136.3 |
| 4 | 39.5 | 39.5 | 4‴″ | 15.7 | 15.7 |
| 5 | 55.3 | 55.4 | 5‴″ | 20.7 | 20.8 |
| 6 | 18.5 | 18.7 | GlcA 1′ | 105.2 | 105.3 |
| 7 | 36.7 | 36.6 | 2′ | 79.2 | 79.3 |
| 8 | 41.5 | 41.6 | 3′ | 81.8 | 82.5 |
| 9 | 46.9 | 47.0 | 4′ | 71.1 | 71.1 |
| 10 | 36.7 | 36.8 | 5′ | 76.8 | 76.9 |
| 11 | 23.7 | 23.8 | 6′ | 172.3 | 172.3 |
| 12 | 124.6 | 124.7 | Glc 1″ | 102.1 | 102.5 |
| 13 | 144.2 | 144.3 | 2″ | 76.8 | 76.3 |
| 14 | 47.5 | 47.6 | 3″ | 78.0 | 78.3 |
| 15 | 67.4 | 67.4 | 4″ | 72.5 | 72.4 |
| 16 | 74.8 | 74.9 | 5″ | 78.0 | 78.1 |
| 17 | 45.0 | 45.1 | 6″ | 63.4 | 63.5 |
| 18 | 41.5 | 41.6 | Gal 1‴ | 100.7 | 101.2 |
| 19 | 46.9 | 46.9 | 2‴ | 76.1 | 76.1 |
| 20 | 31.8 | 31.9 | 3‴ | 75.9 | 75.9 |
| 21 | 41.2 | 41.4 | 4‴ | 71.1 | 71.2 |
| 22 | 72.4 | 72.6 | 5‴ | 78.0 | 77.3 |
| 23 | 27.6 | 27.8 | 6‴ | 62.2 | 61.8 |
| 24 | 16.5 | 16.6 | Rha 1″″ | 102.3 | 102.2 |
| 25 | 15.7 | 15.6 | 2″″ | 72.7 | 72.5 |
| 26 | 17.4 | 17.4 | 3″″ | 72.4 | 72.5 |
| 27 | 21.2 | 21.2 | 4″″ | 73.8 | 73.7 |
| 28 | 62.7 | 62.8 | 5″″ | 69.6 | 69.7 |
| 29 | 33.3 | 33.4 | 6″″ | 17.9 | 18.1 |
| 30 | 25.0 | 25.1 |
© 2019 by the authors. Licensee MDPI, Basel, Switzerland. This article is an open access article distributed under the terms and conditions of the Creative Commons Attribution (CC BY) license (http://creativecommons.org/licenses/by/4.0/).
Share and Cite
Wu, C.; Wu, H.-T.; Wang, Q.; Wang, G.-H.; Yi, X.; Chen, Y.-P.; Zhou, G.-X. Anticandidal Potential of Stem Bark Extract from Schima superba and the Identification of Its Major Anticandidal Compound. Molecules 2019, 24, 1587. https://doi.org/10.3390/molecules24081587
Wu C, Wu H-T, Wang Q, Wang G-H, Yi X, Chen Y-P, Zhou G-X. Anticandidal Potential of Stem Bark Extract from Schima superba and the Identification of Its Major Anticandidal Compound. Molecules. 2019; 24(8):1587. https://doi.org/10.3390/molecules24081587
Chicago/Turabian StyleWu, Chun, Hong-Tan Wu, Qing Wang, Guey-Horng Wang, Xue Yi, Yu-Pei Chen, and Guang-Xiong Zhou. 2019. "Anticandidal Potential of Stem Bark Extract from Schima superba and the Identification of Its Major Anticandidal Compound" Molecules 24, no. 8: 1587. https://doi.org/10.3390/molecules24081587
APA StyleWu, C., Wu, H.-T., Wang, Q., Wang, G.-H., Yi, X., Chen, Y.-P., & Zhou, G.-X. (2019). Anticandidal Potential of Stem Bark Extract from Schima superba and the Identification of Its Major Anticandidal Compound. Molecules, 24(8), 1587. https://doi.org/10.3390/molecules24081587
